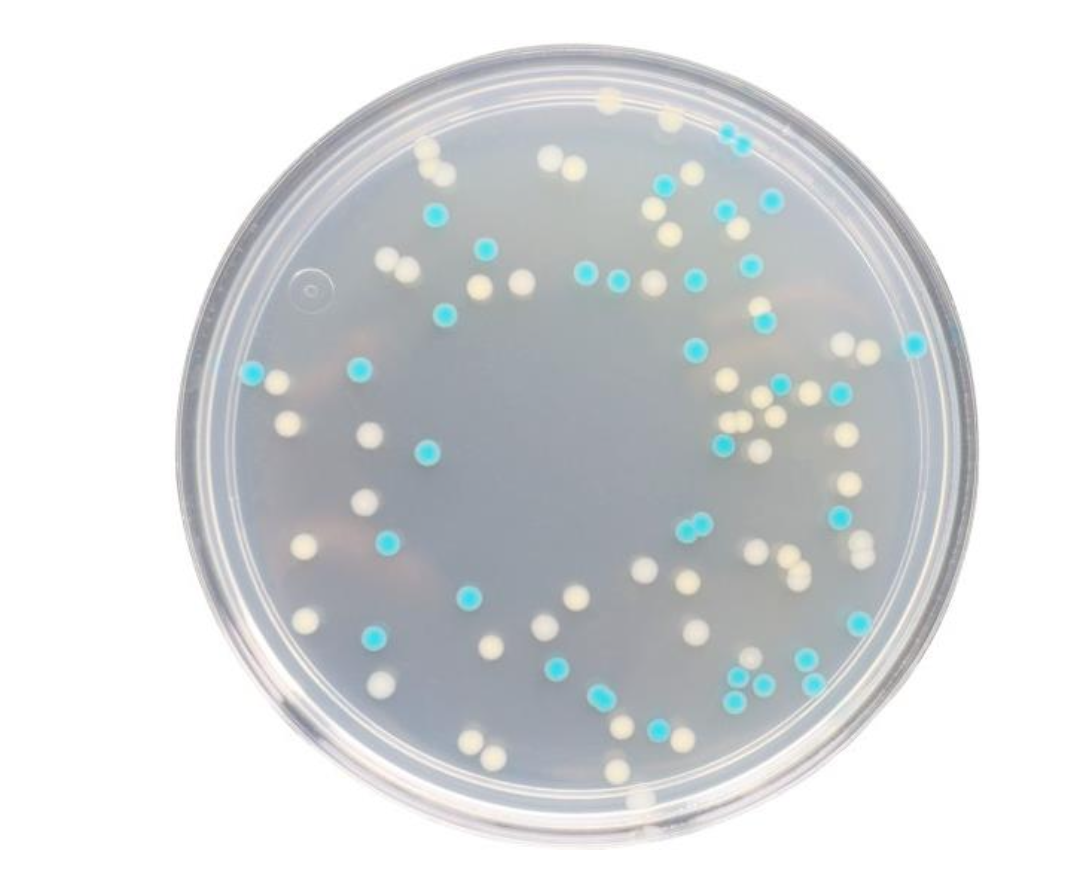

CRM018B Tryptone Bile X-glucuronide Agar (TBX)
$306.40-471.40
CRM018B Dehydrated Culture Medium 500g/bottle Intended Use For the rapid detection of Escherichia coli in food samples. Principle and Interpretation Tryptone provides nitrogen sources, ……
Introduction
CRM018B Dehydrated Culture Medium 500g/bottle
Intended Use
For the rapid detection of Escherichia coli in food samples.
Principle and Interpretation
Tryptone provides nitrogen sources, vitamins, and growth factors.5-Bromo-4-chloro-3-indolyl-β-D-glucuronide (BCIG) acts as a chromogenic substrate. Escherichia coli β-glucuronidase hydrolyzes BCIG, releasing a chromogen that produces blue-green colonies. Bile Salt No.3 inhibits Gram-positive bacteria, particularly Gram-positive bacilli and Enterococcus faecalis. Agar serves as the solidifying agent.
Formulation
| Ingredients | /liter |
| Tryptone | 20.0g |
| Bile Salt No. 3 | 1.5g |
| 5-Bromo-4-chloro-3-indolyl-β-D-glucuronide (BCIG) | 0.075g |
| Agar | 13.0g |
| pH 7.2±0.2 at 25°C | |
Preparation
Weigh 34.6 g of the dry powder and add to 1 L of distilled or purified water. Stir and heat to boiling until fully dissolved. Autoclave at 121°C for 15 minutes, then cool to 50°C.Pour into sterile Petri dishes.
Quality Control
Cultural characteristics observed after incubation at 35-37°C for 24 hours
| Quality control strains | Approx. Inoculum(CFU) | Recovery | Characteristics |
| Escherichia coli ATCC 25922 | 10-100 | PR≥0.7 | Blue-green colonies |
| Escherichia coli CMCC(B)44102 | > 104 | PR≥0.7 | Blue-green colonies |
| Citrobacter freundii ATCC 43864 | > 104 | Growth observed | White colonies |
| Enterococcus faecalis ATCC 29212 | > 104 | G ≤1 | No growth |
Page 1 / 2
Storage and Shelf Life
2-30°C,Keep container tightly closed, avoid direct sunlight. Use before expiry date on the label.
Precautions
1. When weighing the dehydrated medium, please wear masks to avoid causing respiratory system discomfort 2. Keep container tightly closed after using to prevent clumping.
Waste Disposal
Microbiological contamination was disposed by autoclaving at 121°C for 30 minutes.
Revision
On June 14, 2024
Escherichia coli: Blue-green colonies
Other bacteria: White colonies or inhibited/no growth



